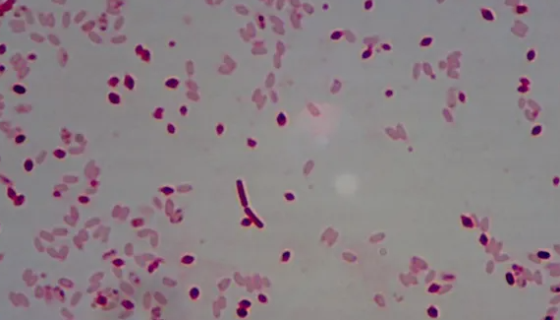
苏云金芽孢杆菌的实验内容与注意事项及保藏方法！
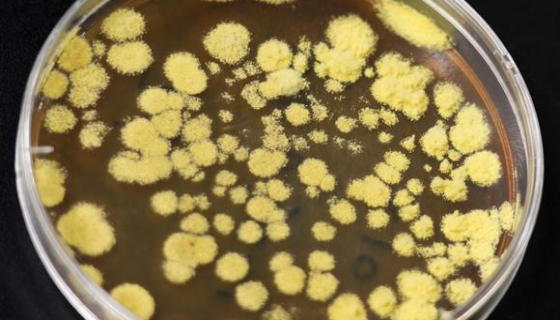
蜡叶散囊菌的培养条件与注意事项及打管说明！
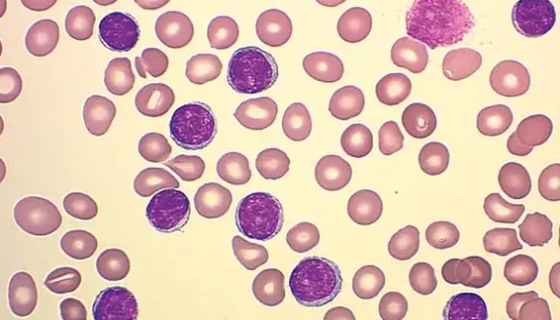
人急性原粒细胞白血病细胞培养的优点与操作步骤！

费氏另类弧菌的形态特征与主要价值及打管说明!
费氏另类弧菌是Aliivibrio属的微生物,原产地为中国。...

ATCC 11874 肉桂链霉菌的培养方法与注意事项!
肉桂链霉菌用于实验和科研检测用,属于菌株类。

小鼠膀胱上皮细胞接受后的处理方法与培养操作规程!
上皮细胞覆盖于身体表面并衬贴于体内空腔器官腔面的细胞。其排列...
苏云金芽孢杆菌的实验内容与注意事项及保藏方法!
苏云金芽孢杆菌,英文名称:Bacillus thuringi...

人真皮毛乳头细胞的运输和保存及使用方法!
真皮毛乳头细胞位于毛囊基底部,是一类成纤维细胞。在毛囊发育早...

鼠伤寒沙门氏菌TA100的性质、用途与生产工艺!
鼠伤寒沙门氏菌,是一群非适应性或泛嗜性的沙门氏菌,具有广泛的...
蜡叶散囊菌的培养条件与注意事项及打管说明!
蜡叶散囊菌是一种斜面培养物,一般是闭囊壳球形、近球形,子囊近...

谷氨酸棒杆菌的使用范围及培养与保存方法!
谷氨酸棒杆菌是Corynebacterium属的微生物,原产...
人急性原粒细胞白血病细胞培养的优点与操作步骤!
Kasumi-1细胞具有人急性淋巴白血病细胞的典型特征,是研...